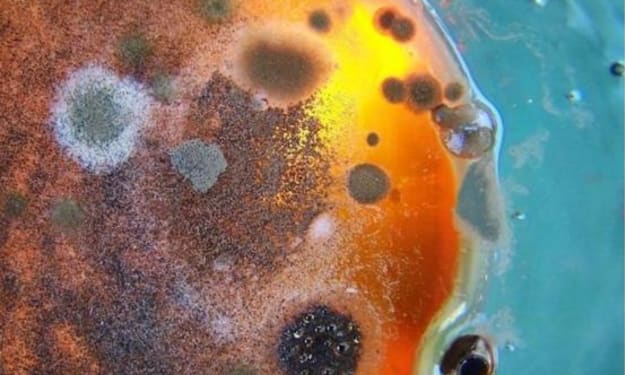

adalberto alejandrina
Bio
scientific exploration
Stories (54)
Filter by community
Six months of warning is not enough to stop an asteroid from hitting Earth, we need 5 to 10 years!
NASA has simulated a scenario in which an asteroid is approaching the Earth and will hit it in six months. Experts don't think there's enough time to stop it. We need at least five years to deflect the asteroid.
By adalberto alejandrina3 years ago in Earth
The purpose of stem cell research is to reveal the secret of anti-aging growth!
When we study stem cells, what is the purpose of it? It is anti-aging and anti-aging. Birth, old age, sickness and death are human nature, but everyone wants to live a better life, everyone wants to have a good start and a good end, and can enjoy the happiness of a family. When we face the disease, we can predict the risk of the disease in advance and avoid some risks. Here are some of our most common requests.
By adalberto alejandrina3 years ago in Earth
The solar system is about to be invaded! A star is approaching us, or causing a comet to threaten Earth
In the novel "Three-Body Problem", the three-body people know the existence of the earth, invade the solar system on a large scale, and prepare to fight to the death with human beings.
By adalberto alejandrina3 years ago in Earth
Do men have an advantage as astronauts? No, women have an advantage
Whenever we mention those dangerous occupations, we immediately think of a tall and heroic male image. Of course, this is not because of the sexism of Luo Shizi. If anyone in this day and age will talk about gender, then It's absolutely ridiculous.
By adalberto alejandrina3 years ago in Earth
Scientists have found that mantis shrimp are good at "sneak attack", and will "snap their fingers" in a few days?
The diversity of global populations allows us to know that in addition to humans, there are many other types of creatures in the world today. For example, some animals are very ferocious, some are burly animals, and some animals are cute and cute. Except for this kind of animal, There are also many green plants in nature.
By adalberto alejandrina3 years ago in Earth
In the past 100 years, human lifespan has doubled, and it is expected to exceed 200 years in the future
According to reports, a very exciting and gratifying research result is that in the past 100 years, with the faster and faster development of human beings, the average life expectancy of human beings has also been significantly improved, compared to before the 20th century. It seems that it has been increased by about 1 times.
By adalberto alejandrina3 years ago in Earth
Finally found extraterrestrial life? Scientists: Massive 'mushrooms' emerging from Martian soil
This is shocking and exciting news! According to reports, a large number of foreign scientists now say that through the data photos returned by the Mars probe, a large number of fungal life similar to puffball bacteria can be seen emerging from the soil of Mars. This discovery also means that, Humans have finally found extraterrestrial life, however, is this the answer?
By adalberto alejandrina3 years ago in Earth
Strange photos were taken on Venus, and moving objects appeared on the surface, causing a sensation in the scientific community
The eight planets in the solar system have unique appearances and different sizes. Although the earth is not the largest, it is the most special one, because the surface of this planet has both land and ocean, and there are many green areas on the land. , a feature not found on other planets. Once upon a time, Venus was considered Earth's sister planet because the two were similar in many ways. For example, the mass of Venus is 0.82 times that of Earth, its radius is 0.95 times that of Earth, and its gravity is 0.9 times that of Earth.
By adalberto alejandrina3 years ago in Earth
Know better than you what looks can attract your AI
Appearance preferences may change over time (such as having a mustache or wearing a monocle), but in any case, top social status can not only attract a significant other, it may even help you get promoted, or make it easier to meet powerful elites. Despite the multifaceted social impact of "look", the mechanisms behind these preferences remain unfathomable. Rarely do we make a "conscious and logical judgment" about a person's appearance first, and often guess the cause after experiencing the feeling, but artificial intelligence may be able to help solve this problem.
By adalberto alejandrina3 years ago in Earth
Lufeng discovers about 3-year-old dinosaur larvae fossils · Tracking | Lufeng this dinosaur baby was drowned by floods
In the Early Jurassic strata in Lufeng County, Yunnan Province, about 200 million years ago, scientists discovered a drowned 3-year-old sauropod dinosaur fossil. The discovery was recently published in the international journal Acta Geologica Sinica.
By adalberto alejandrina3 years ago in Earth
From the almost "car accident" of Starlink satellites, do Internet satellites really only have advantages?
I believe that many friends in front of the screen are no longer familiar with Musk. As the founder of SpaceX, Tesla and Neuralink, he can be called a generation of Internet leaders. On the 19th, the SpaceX starship prototype SN15 was tested in Texas, USA. The live broadcast showed that SN15 flew to an altitude of 10 kilometers and successfully landed at the Texas base 6 minutes after takeoff. It has successfully sent humans to space, completed another commercial manned flight, and plans to send humans to Mars in 2025.
By adalberto alejandrina3 years ago in Earth
novel! This giant exoplanet has been photographed by scientists, and its orbit is quite strange
Through the Young Exoplanet Survey (YSES) project, astronomers have directly photographed a gas giant in an orbit that is unusually large. It is as far from its star as Jupiter is 20 times from the Sun.
By adalberto alejandrina3 years ago in Earth